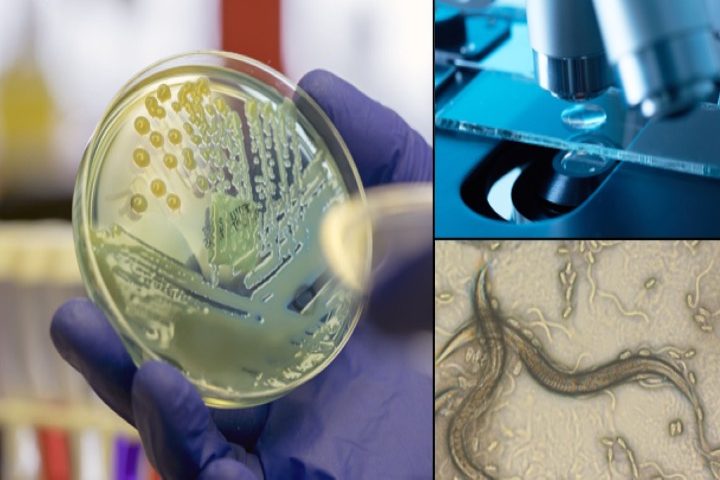

Biologi
Främjar förståelsen av levande system genom utbildning och forskning.
För att öka inverkan av vår forskning förbättrar vi förståelsen av biologiska mekanismer, från molekyler till levande system. Vi integrerar grundläggande vetenskaper för att utforska organismernas komplexitet och deras interaktioner med miljön genom tvärvetenskapliga ansatser. Därför prioriterar vår forskning effekterna av miljöstressorer, såsom föroreningar och klimatförändringar, på modellorganismer och ekosystem, med en kombination av molekylära, biomedicinska och ekologiska perspektiv.
Om forskningsämnet
Ämnesuppgifter
Kontaktperson
Vetenskapsområden
- Naturvetenskap
Forskningsområden
- Cellbiologi
- Ekologi
- Fysiologi
- Genetik
- Immunologi
- Mikrobiologi
- Miljövetenskap
- Molekylärbiologi
- Toxikologi
- Utvecklingsbiologi
Inom biologi är våra huvudsakliga forskningsområden:
- Miljö och människors hälsa – Undersöker föroreningars påverkan på miljön och människors hälsa, inklusive exponering, toxikologiska effekter och kopplingar till olika sjukdomar.
- Molekylära och cellulära mekanismer – Utforskar de molekylära grunderna för fysiologiska processer som är involverade i acklimatisering och organismers respons på miljöstressorer.
- Ekologiska och evolutionära processer – Studerar interaktioner mellan växter, jord och mikroorganismer, kolcykeln samt anpassningens och acklimatiseringens roll för att bibehålla ekosystemens funktionalitet under förändrade miljöförhållanden.
- Mikrobiella processer och tillämpningar - Förstår effekterna av läkemedelsföroreningar på mikrobiella system och utvecklar probiotikabaserade metoder för att förebygga infektioner och inflammatoriska sjukdomar.
Vi tillämpar avancerade teknologier, inklusive omik-metoder, högupplöst bildanalys samt molekylära och bioanalytiska metoder i kombination med olika modellorganismer. Vår forskning är starkt multidisciplinär, och vi utökar användningen av AI-driven dataanalys för att förbättra vår förmåga att identifiera mönster i storskaliga miljö- och biologiska data. Genom att stärka samarbeten med industri, beslutsfattare och internationella forskningsnätverk säkerställer vi att våra forskningsresultat omsätts i innovativa strategier för att minska föroreningar, förbättra regleringsramverk samt utveckla hållbara lösningar för bevarande av biologisk mångfald och hälsa.
Forskare
- Andi Alijagic
- Magdalena Andersson
- Håkan Berg
- Yared Bezabhe
- Johanna Björklund
- Alf Ekblad
- Magnus Engwall
- Manon Fallet
- Lara García Campa
- Ulf Hanell
- Jana Jass
- Steffen Keiter
- Hazem Khalaf
- Lina Lundin
- Carina Modig
- Luis Morales
- Per-Erik Olsson
- Ingrid Rijk
- Nikolai Scherbak
- Erica Selin
- Erik Sjöstedt
- Jörgen Stenlund
- Adam Tillo
- Tao Zhao
- Denisa Avdouli, Doktorand
- Yared Bezabhe, Doktorand
- Ulf Hanell, Doktorand
- Berkay Paylar, Doktorand
- Marina Ricarte, Doktorand
- Gladys Sergon, Doktorand
- Jonas Zetzsche, Doktorand
Forskargrupper
- EnForce
- Forskargruppen för växtfysiologi och cellkommunikation i växter
- Interaktion och lärande i högskolepedagogisk praktik (ILHP)
- Miljö och hälsa
- Molekylär Akvatisk Toxikologi
- Molekylärbiologi
- STEAM - undervisning med inriktning på hållbar utveckling
- Systemekologi
- Systemimmunologi och mikrobiologi
Forskningsprojekt
Pågående projekt
- Androgenreceptorer: ligandberoende genreglering
- BALANCE - Behandling av lågförorenad jord med biokol tillverkad av organiskt avfall för hållbar resursanvändning och cirkulär ekonomi
- BioLearning - Using bioindicators, biomarker profiles and machine learning to improve water quality analysis
- Biological responses to pharmaceuticals and antibiotics in the environment
- Cell Painting-based toxicophenomics
- Characterizing probiotic Lactobacillus bioactive compounds
- CoLiBRI - Cobalt and Lithium speciation, toxicity, and Bacterial community Regulations at the sediment-water-Interface
- Dechiffrera sameffekterna av svar på klimatförändringar och perfluoralkylämnen på zebrafisken
- Effektbaserad strategi för identifiering och bedömning av potentiella hälsoeffekter av farliga organiska kemikalier i inomhusmiljöer
- Ektomykorrhizamycel - dess produktion och omsättning samt betydelse för markens kolförråd
- Fish & Cocktails
- Generation and persistence of novel antibiotic resistance in bacteria
- Identifiera: Identifiering av miljö- och hälsoskadliga polycykliska aromatiska ämnen (PAC) för en förbättrad riskbedömning av förorenade områden
- Identifiering av virala RNA sekvensvariationer och virala/cellulära proteiner involverade i regleringen av flavivirus replikering: implikationer för vaccinutveckling
- Influence of lactobacilli on expression of key proteins involved in miRNA biogenesis
- Inverkan av ljuskvalitet på acklimering och produktion av såddplantor från barrträd
- Kolisotopfraktionering under skogsväxters och markorganismers respiration
- Laktobakterier som produktions- och leveranssystem för rekombinanta orala vacciner
- MicroSens - Förbättra smakuppfattning genom att ändra oral mikrobiota
- Mixture-Risk
- NanoSafety2
- PAC-Risk
- PARC - Partnerskap för bedömning av risker från kemikalier
- PFAS-Risk
- Photoreceptor interactions in plant perception of ultraviolet and blue light
- Plant responses to ultraviolet radiation and blue light: from perception to crop production
- PLASTIC-Risk
- RESPONSE - Towards a risk-based assessment of microplastic pollution in marine ecosystems
- SEASON - Säsongsvariationers betydelse för distribution, tillgänglighet och toxicitet för kemiska föroreningar vid gränsytan mellan sediment och vatten
- Sexdeterminering och differentiering
- Statusen hos ekosystemfunktioner i förorenade marker utvärderade in situ med hjälp av växt- och mikrobindikatorer
- Studie av effekterna av perfluoroktan sulfonsyraföreningar (PFC) på fettsyrametabolism under fågelutveckling
- Tillsats av biokol för stabilisering av föroreningar och ekologisk restaurering av marken
- Transgenerational Effects of Pollutants
Avslutade projekt
- APPLICERA: Applicable site-specific environmental risk assessment of contaminated soils
- Avian developmental toxicity of perfluorochemicals: species sensitivity differences and mechanisms of action
- Bioanalytical screening of POPs in otters
- Bioanalytical studies of soils and sediments
- BioImpakt - Biological impact of persistent perfluorinated compounds
- Biokol - Från organiskt avfall till resurs för nyttiggörande av jordavfall
- BIOSLUDGE - Biologiska effekter av slam från reningsverk
- Chemical and toxicological characterisation of PAHs and related compounds in road dust
- CleanSea
- EPHEMARE - Ecotoxicological effects of microplastics in marine ecosystems
- Hållbar livsmedelsproduktion i Sverige - att odla och äta från perenna system
- Hälsodiagnostik i miljön
- Interaktioner mellan metallotionein och p53: potentiell roll i tumörbildning
- Kemiska risker med plast i det marina ekosystemet
- Mikroplaster i Sveriges stora sjöar
- Mjukgörare: Immune och Metabolism
- NanoSafety1
- NANOSIGN
- Probiotic Lactobacillus modulation of cellular immune responses
- Skolmåltiden som pedagogiskt verktyg
- Sköldkörtel och Hjärna
- SOILEFFECT: Development of bioreporter-based survey and health risk assessment of toxic chemicals in contaminated areas
- SOILTOX: processoptimering och innovation av marksaneringsmetoder med hjälp av bioanalytiska toxicitetstester
- SYNERGY - Bestämning av biologiska effekter av komplexa blandningar för förbättrad riskvärdering
- Utveckling av platsspecifik miljökvalitetsanalys